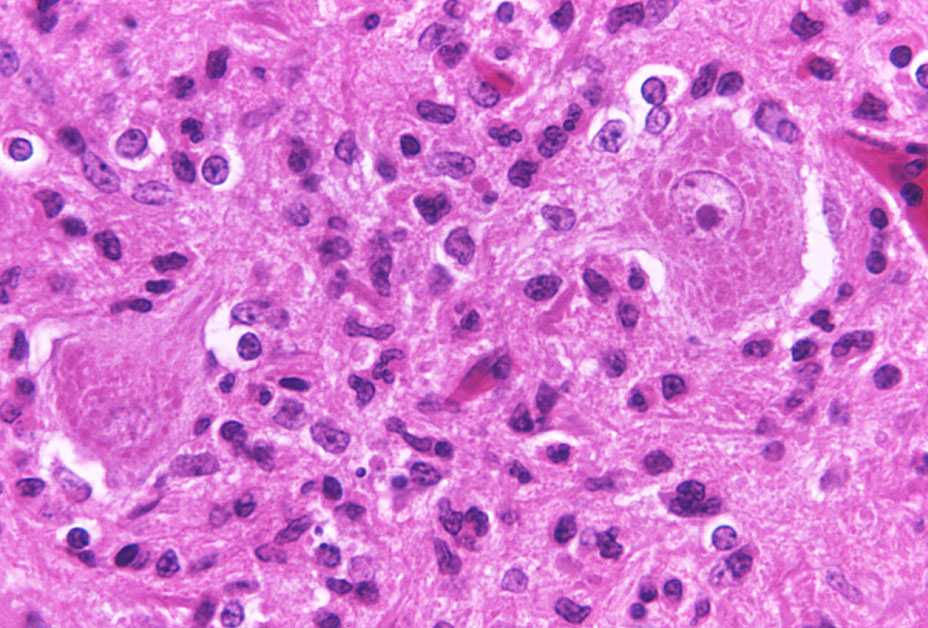
Brain cells with rabies

Rabies
[rey-beez]

Rabies is a disease spread from bites by rabid animals. Without treatment, rabies causes death, but if you receive a series of shots after you are bitten, before any symptoms appear, you can prevent infection. That's why it's important to see a doctor as soon as you're bitten by an animal. In the U.S., raccoons, skunks, foxes, and bats are the main sources of rabies. Contact with bats should be carefully evaluated. Even though their bites are small and may not seem serious, you should always see a doctor if you think a bat might have bitten you. To help stay rabies free, keep a safe distance from wild and unfamiliar animals.
Quiz
Key Facts
- Rabies can kill unless you receive a series of rabies shots before you have symptoms.
- In many parts of the world, the vast majority of human rabies cases come from being bitten by rabid dogs.
- In the early 1900s, 100 people died of rabies each year in the U.S. By the 1990s, that dropped to 1 or 2 a year.
- Rabies spreads through the nerves to the brain. Once symptoms of rabies appear, there is no treatment and it is almost always fatal.
- In the United States, the main sources of rabies are wild animals, such as raccoons, skunks, foxes, and bats.
Media
Prevention Tips
-
Visit your veterinarian with your pet on a regular basis. Keep rabies vaccinations up-to-date for all cats, dogs, and ferrets.
-
Keep control of your pets—cats and ferrets should be indoors, and dogs should not be allowed to run free or unsupervised.
-
Spay or neuter your pets to help reduce the number of unwanted animals that may not be properly cared for or vaccinated regularly.
-
Keep a safe distance from wild animals. If you see a dead animal or a live one acting strangely, call an animal control professional.
-
Keep your trash cans closed up tight, and keep food and water indoors. You don’t want to attract wild animals to your home.
-
If you’re bitten by an animal, wash the wound with soap and water for 15 minutes, and call a doctor.
- Page last reviewed: March 3, 2016
- Page last updated: March 3, 2016
- Content source:
- Centers for Disease Control and Prevention
- Page maintained by: Office of Associate Director of Communication, Division of Public Affairs


 ShareCompartir
ShareCompartir